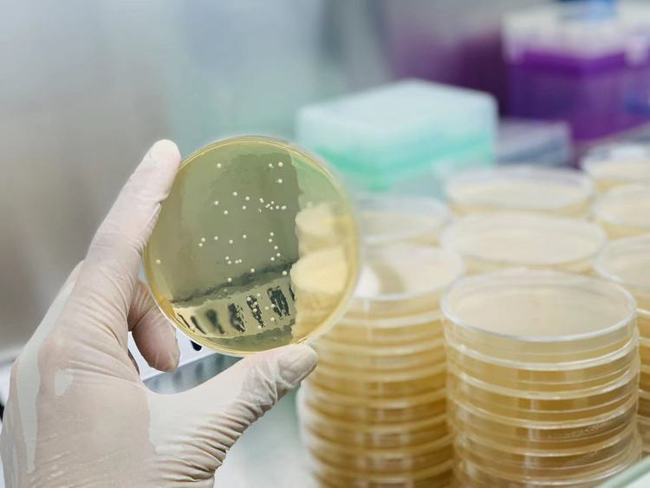
粪菌移植、预测免疫疗法,这家肠道微生态治疗公司获新融资休闲区蓝鸢梦想 - Www.slyday.coM 粪菌移植、预测免疫疗法,这家肠道微生态治疗公司获新融资休闲区蓝鸢梦想 - Www.slyday.coM

粪菌移植、预测免疫疗法,这家肠道微生态治疗公司获新融资
澎湃新闻记者 贺梨萍
11月27日,中国首家专注于肠道微生态治疗的AI制药公司深圳未知君生物科技有限公司宣布完成数千万美元B+轮融资。
微生物组被称作人体健康的“晴雨表”,一个50千克重的人,体内微生物约有1.5千克。2007 年底,美国国立卫生研究院(NIH)宣布投入 1.15 亿美元正式启动“人类微生物组计划”(HMP),旨在收集跟人体相关的所有微生物基因组,探讨微生物群落的丰度对人体的影响,从而帮助了解其在人类健康和疾病中的作用。
随着这一领域研究的深入,相关企业也随之带动兴起。11月27日,中国首家专注于肠道微生态治疗的AI制药公司深圳未知君生物科技有限公司(下称“未知君”)宣布完成数千万美元B+轮融资,这是迄今为止国内微生态制药行业规模最大的融资事件。
该轮融资由春华资本和⾼榕资本领投,五源资本(原晨兴资本)、君联资本、熠美资本和雅亿资本跟投。据悉,资金将主要用于研究团队2021年临床试验的开展、药物管线的研发,以及对现有技术平台的持续研发和深化拓展。
未知君创始人谭验博士表示,“随着美国几家微生物制药公司临床试验的顺利进行,微生态制药赛道在国际上愈发受到重视,得到包括传统药厂、监管机构和资本市场在内各方的认可支持。”他认为,现在微生态制药行业正逐渐走向一个更加成熟的阶段,“希望未知君能代表中国在这个行业中跻身国际一流行列。”
天眼查数据显示,未知君成立于2017年11月,注册资本500万人民币。公司官网介绍,公司系中国首家专注于肠道微生态治疗的AI制药公司,旨在通过粪菌移植、配方菌等微生物治疗方式,实现肠道及其他系统性疾病的缓解或治疗。其核心研发团队由来自于美国博德研究所(Broad Institute)、哈佛大学、麻省理工学院、斯坦福大学、纽约大学西奈山医学院和约翰霍普金斯大学等顶级高校和研究机构的科学家组成。
值得注意的是,不同于传统的“细胞-动物模型-人体”的医药研发路径,未知君利用的是一种创新的科研模式和独特的药物研发平台,将“人工智能+生物信息分析技术”,与肠道微生态技术相结合,以此提升新药研发效率和成功率。目前,其在⼈⼯智能方面搭建了多组学计算平台、关键菌发现平台和微生物知识库平台,在⽣物技术方面搭建了培养组学平台、动物模型验证平台和微生态药物生产平台。
据介绍,目前未知君已在肿瘤免疫治疗、神经系统和免疫性疾病等适应症完成布局,拥有4条自研微生态药物管线。通过研究者发起的临床试验(IIT),未知君已与北京大学肿瘤医院、上海新华医院、南方医科大学南方医院等国内多家知名医疗机构开展了肠道微生态临床研究合作。
据悉,未知君已向美国食品药品监督管理局(FDA)提交了关于aGvHD(移植物抗宿主病)项目的新药临床试验申请(IND)。aGVHD一般指发生在造血干细胞移植后的一种特异的免疫现象,是移植物组织中的免疫活性细胞与组织抗原不相容的受者组织之间的反应。未知君称,通过后,其将拥有亚洲第一款获得美国临床批件的FMT(粪菌移植)药物,及中国第一款获得美国临床批件的微生物药物。
值得一提的是,在《麻省理工科技评论》近日发布的2020年“50 家聪明公司” 榜单中,未知君即跻身其中,上榜理由为其以肠道微生物为生物标志物,对于肿瘤患者接受 PD-1治疗的预测精度已达国际领先水平。
